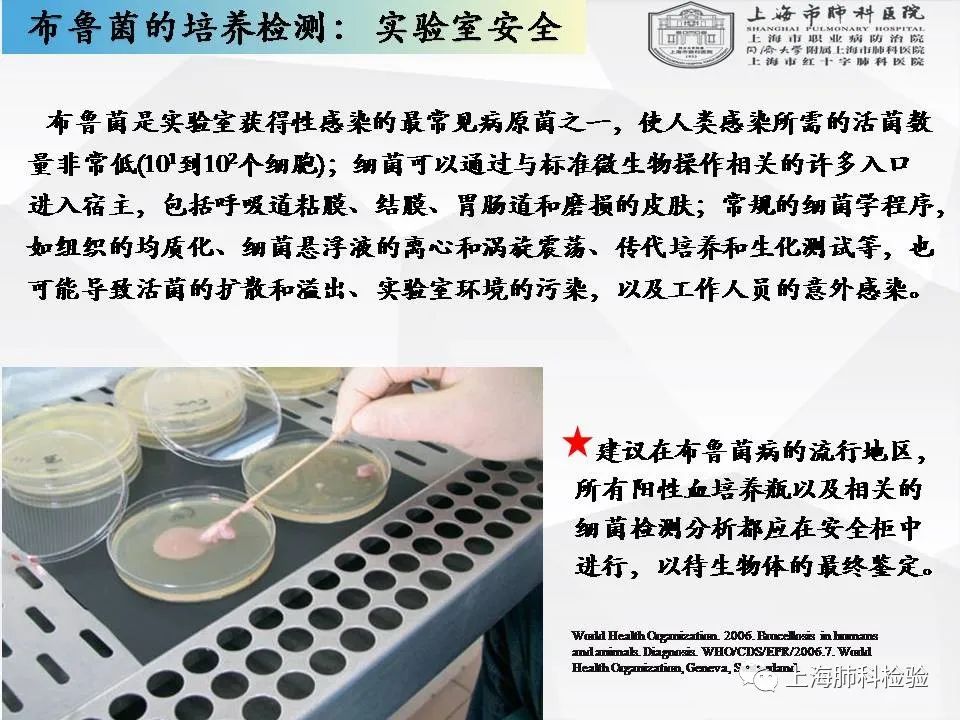

● 很快,八月即将过去,这些日子以来,上海肺科检验被一些波折、历练以及一些恶意的侵权行为所困扰,幸运的是,有着大家的一贯支持!我们才能走到现在!我们乐意做知识的传播者!请收下我们为医师节所献上(chidao)的礼物!

|
声明:
1、凡本网注明“来源:小桔灯网”的所有作品,均为本网合法拥有版权或有权使用的作品,转载需联系授权。
2、凡本网注明“来源:XXX(非小桔灯网)”的作品,均转载自其它媒体,转载目的在于传递更多信息,并不代表本网赞同其观点和对其真实性负责。其版权归原作者所有,如有侵权请联系删除。
3、所有再转载者需自行获得原作者授权并注明来源。